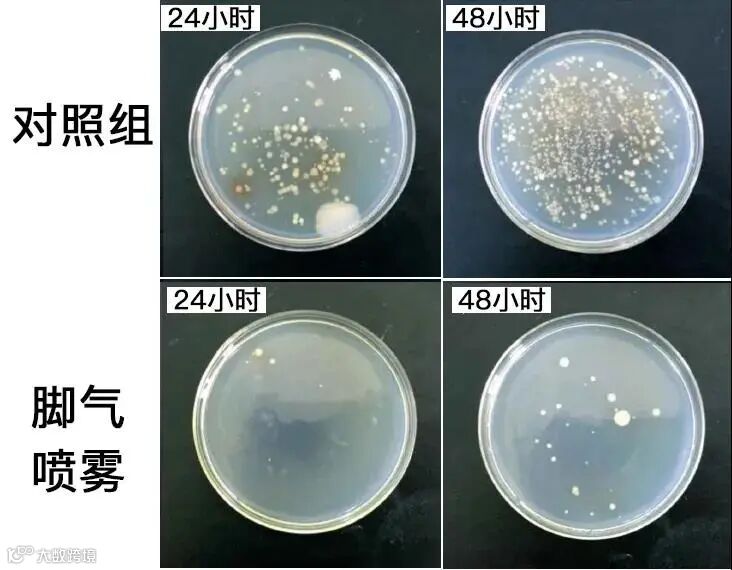

如果说臭味也分等级的话,那么脚臭一定位居榜首。那独特的酸爽味和挥之不去的窒息感,简直就是生化武器。

尤其是夏天,很多朋友估计都遇到这样的尴尬。就是去朋友家做客、专柜试鞋、日料店吃饭……每次脱鞋都是“大型社死现场”。

脚臭顶多恶心下别人,脚痒遭罪的就是自己了。晚上痒的睡不着,脚趾使劲的在被子上搓,用手指拼命的挠,不仅无济于事,连手指都是脚臭味。

如果你有脚臭、脚痒的症状,一定要注意了,很可能是得了脚气!
脚气不仅仅是是脚臭、脚痒,脚部还会出现脱皮、水疱、干裂。严重的还会溃疡、烂脚,一出脚汗,像往伤口上撒盐,火辣辣的疼!

尤其是女生,脚部脱皮、干裂、灰指甲太影响形象了,夏天连好看的凉鞋、高跟鞋都不敢穿出去!

☛脚气、脚臭到底怎么回事?
脚气又被称为“香港脚”,在医学上被称为足癣。它是由于脚部皮肤被真菌感染所致,出现脱皮、水疱、干裂等症状,还会伴有瘙痒,严重的脚部还会慢慢烂掉!

*图片来源于百科医典
脚臭不一定有脚气,但脚气常常伴随着脚臭。脚臭是因为脚部存在细菌,夏天容易出汗,脚汗可都是脚部细菌的“营养大餐”,脚汗被细菌分解,散发大量难闻的臭味,就是脚臭!

更可怕的是,脚气还有传染性,往往一人有脚气,全家被传染!
比如你刚脱下的臭袜子,用过的脚盆、毛巾都沾满了皮屑,一不小心就跑到家人身上。
☛脚气为何总是治不好,易复发?
小编也是很不幸,不知道啥时候得了脚气,好多年了,每年都要犯2~3次,试过很多方法,总是治不好。
比如用常用的泡脚,药浴包、生姜、醋一堆,但是真有用,我们也不用这么痛苦了。

还有涂药膏,一开始有效,但是很容易激素依赖,一旦停用,脚气便卷土重来。而且药味难闻,涂抹麻烦,脚臭夹杂着药味,涂完更睡不着觉了。

而且以上方法都只针对脚部,我们穿的袜子、鞋子都沾有真菌、细菌,难以清洗掉,穿上后,又重新传染回脚上,这也是导致脚气复发的主要原因之一。

脚气难受又难缠,小编以为这辈子要顶着它过一辈子了,直到遇到了足适爽喷剂才知道,原来只要喷一喷,伴随多年的脚气就可以轻松解决!
小编今天就把这款「脚气克星」推荐给你
柏参足适爽保健喷剂
草本植物配方,抑菌率高达99.8%
喷一喷,5秒除臭味、止瘙痒
喷脚部、喷袜子、喷鞋内
快速、安全、有效
多方面断绝细菌真菌源头
远离脚气,告别脚臭、瘙痒~

推荐理由:
1、河南中医药大学博士专家团队研发,荣获国家专利,喷一喷,除臭止痒,5秒起效;
2、含有苦参、野菊花、侧柏等提取物,专业机构认证,抑菌率高达99.8%,从根源去除脚气、脚臭;
3、纯草本植物配方,安全无激素,大人小孩放心用;
4、喷雾设计,喷脚部、喷鞋袜,全方位杀菌,减少复发几率。
扫描下方二维码,即可购买

01
自古以来的“脚气天敌”
喷一喷,5秒除臭味、止瘙痒
这款足适爽是由河南中医药大学博士专家团队研发而成的,负责人张博士说:苦参有非常强的抑菌作用,自古以来就是“脚气天敌”。只要抹在脚上,10年脚气、脚臭全消!

唐代文学家柳宗元也曾得过脚气,并在给友人的信中写道:“仆自谪过以来,益少志虑。居南中九年,增脚气病,渐不喜闹。”
后来大夫给他开了苦参的药,抹在脚上,脚气病才渐渐好起来,好了之后的柳宗元文学成就也越来越高,终成唐宋八大家之一。

大家都知道,足球运动员每天数小时的练球,加上球鞋闷脚,会出大量脚汗,不一定有脚气,但几乎人人有脚臭!
所以球队常常备着苦参。提到它,球员们都赞叹地说:“稍微喷一喷就能除臭味,有它才能毫不畏惧地在球场驰骋!”

《本草纲目》也记载它:去湿热、疗瘙痒、止溃疡、消臭味,是名副其实的“脚气天敌”。

研发团队正是基于《本草纲目》中的记载,同时研究了上百种药草,经过300多天、523次调试,最终以苦参为主,辅以野菊花、白鲜皮、侧柏、土茯苓4大草本植物,研制出了这款足适爽喷剂。

同时也拿到了国家知识产权局的发明专利证书。要知道,一个专利的审核时间快抵得上研发时间了,不是随便一款产品都能拿到的,可见其含金量之高。

喷一喷,5秒除臭味、止瘙痒,喷一次舒服一整天!
多年脚气困扰者小编的试用体验
↓↓↓
小编得脚气好多年了,泡过脚,抹过药,但总是好不了,每年反复2~3次,直到遇见了足适爽,才知道喷一喷就可以轻松去脚气。
晚上脚气犯的时候,喷一喷在脚上,脚上瞬间感觉清清凉凉的,没几秒就不痒了,连脚臭味也淡了,特舒服。
早上出门前再喷一喷,一天都不痒,下班回家后脱掉鞋子,也没有恶心的臭味了!使用时,也会对袜子、鞋子内喷一喷,臭味全消!
使用一个月后已经完全好了。当时多备了一瓶以防复发,结果半年多了没用上。

扫描下方二维码,即可购买

02
专业机构认证,抑菌率达99.8%
从根源去除脚气、脚臭
上面说过,脚气的根源是由于脚部皮肤被真菌感染所致,脚臭是因为脚汗被细菌当作食物分解后散发出异戊酸——即我们闻到的脚臭味。
闷在鞋内一天的脚部可以滋生100万个菌落,比马桶还脏!所以想要彻底解决脚气、脚臭,灭掉脚部的菌落是关键!

市面上很多除脚臭产品都是用香味遮盖,没有从根本上解决细菌问题,这是没办法彻底消除掉脚臭的,更不要说脚气了。

足适爽中含有从苦参、野菊花、白鲜皮中提取出来的草本精华。喷一喷,脚上的细菌立刻失去活性,不再分解脚上的汗液,臭味也就自然消失了。

*显微镜下,喷之前细菌活跃(左图),喷完足适爽后立刻失去活性(右图)。
长期使用,脚部菌落也会越来越少,脚部皮肤也会形成保护膜,长期保护你的脚部,即使出再多汗,没有细菌,也不会产生脚臭。

抑菌效果真的这么强?我们再做个简单的抑菌对照实验。对照组,48小时后,已经被菌落完全占领!
而喷了足适爽的培养皿,只有零星几个菌落。也就是说,喷一次,至少可以管用2天!效果的确很强!
河南科高检测机构也给出了更加专业的检测结果:它对大肠杆菌、金黄色葡萄球菌的灭活率高达99.8%,远高于国家标准90%。

*河南科高是河南院士工作站,河南省科学院实验室,中美联合实验室。它的认可,足以证明足适爽喷剂的效果超棒!
除了除臭,止痒也是非常重要的,脚痒是因为受到热刺激所致,尤其是刚用热水洗完脚时更是痒的难受。
足适爽加入了土茯苓、侧柏叶植物精华,它们有清热燥湿、凉血止血的功效,喷上去凉凉的,彷佛泡在泉水里一样舒服,没几秒就不痒了。

脚部皮肤自身的恢复能力也很强,只要你给它一个健康的足部环境,脱皮、干裂等就会渐渐消失,脚部很快就能长出健康细腻的新皮。

医学博士菲尔曼也用它对256位足癣人群做了临床实验,结果显示:
每天喷一次的人,比没有喷脚的人,脚臭、瘙痒、脱皮、水疱、干裂、溃烂发生率明显降低,脚部皮肤细腻度也明显提升!

@山东王先生,36岁
被脚气困扰多年,也不知道被谁传染的,脚气犯的时候一晚上睡不着觉,脚臭的更是被老婆嫌弃,不愿意跟我睡一起!
还好老婆还是关心我的,给我买了足适爽。喷一喷几秒就不痒了,当晚就睡了个安稳觉,早上出门再喷一喷,一天都很舒爽,最重要的是脚不臭了,跟老婆的关系都变好了!

@广东陈女士,28岁
我脚痒的厉害,脚底和边缘脱皮,非常难看,严重的时候脚趾缝都裂开了,洗脚穿袜子都疼~折磨了我整整10年!
后来中医朋友推荐了它,脚趾脚缝、脚背脚底全部喷一遍,你猜怎么着?
当天就不痒了!一个礼拜,脚趾溃烂就开始好转,脚底皮肤变软长出新皮。现在用了2瓶,我的脚已经完全恢复健康,根本看不出来曾经还得过脚气!

扫描下方二维码,即可购买

03
草本植物配方,无激素
喷一喷轻松去脚气
这款足适爽以草本植物配方为主,不含激素不依赖,孩子也可以放心使用。
小编最喜欢的就是它的喷雾设计,使用的时候不用接触脚部,不会沾染到脚臭味。

喷雾非常细腻,可以深入到每个脚趾缝,细菌真菌藏的再隐蔽也不怕!

相比于药膏,它还可以喷袜子、喷鞋内,全方位隔绝细菌危害,减少复发几率,非常贴心、方便!

要知道,脚气复发的主要原因之一就是袜子、鞋内的细菌真菌重新传染回脚部导致的。

小编一开始家里就常备2瓶,一瓶放床头,每天晚上喷一喷,睡个好觉,早上起床再喷一喷,舒服一整天;

另一瓶放鞋柜,定期喷一喷鞋子、袜子,不仅是为了消灭细菌,也可以消除异味,家里来了客人,也不会尴尬。
扫描下方二维码,即可购买

04
高性价比,月销17578瓶
平均每3分钟卖出1瓶
脚气不是什么大病,但是犯起病来真是令人发狂。
痒的时候简直痒到了心里,自己整晚睡不着,还影响家人休息,休息不好还会耽误工作。
脚臭更是要命,严重影响形象,去朋友家、陪对象逛街试鞋等需要脱鞋的场合,更是尴尬极了!
关键还会传染,一人染上全家遭殃!

与其继续受脚气、脚臭折磨,不如试试这款足适爽喷雾,植物草本成分,无激素不依赖。
滋滋滋…一喷5秒去臭味,止瘙痒,舒服一整天!一周长出细嫩新皮,告别10年脚气病!
关键一瓶才39.9元!与市面上动不动就60、70元的喷雾相比划算多了!

*这款某宝热门喷雾,售价60多,评论区也藏着几百条差评!朋友们要擦亮眼睛!
足适爽以其强大的效果也赢得了众多消费者的认可,最高月销达到17578瓶,什么概念呢?就是平均不到3分钟就卖出1瓶!
据统计和回访,这其中有27.34%的订单其实是来自回头客,因为自己用过觉得靠谱,不少客户准备买来送给父母和朋友的!

*数据截止于2021年4月。
现在购买还有福利赠送哦!
福利1
便携小喷瓶
足适爽一瓶200ml,能喷600次!放着家里用正合适!
平时出差、旅行,可以用赠送的便携小喷瓶,才一根手指粗,口袋里都能放得下!非常方便!

福利2
精油泡泡足浴球
脚气、脚臭严重,平时也要勤洗脚,保持脚部卫生,洗脚时搭配这款精油泡泡足浴球最好不过了。
从薰衣草、姜根、迷迭香三种植物中,萃取天然精油,健康安全,温和滋养。泡脚时放一颗,促进代谢,加速血液循环,皮肤越泡越嫩。

它还有抑菌除臭的作用,搭配足适爽使用,去脚气、脚臭更有效!

——柏参足适爽保健喷剂——
喷一喷,5秒去脚臭、止瘙痒
日常价98元/瓶
粉丝专享折扣价39.9元/瓶
买2送1(26.6元/瓶)
买3送2(23.94元/瓶)
购3瓶以上就送小喷瓶+足浴球
(1瓶起效,3瓶巩固,多的可以送父母)
3瓶优惠后才79.8元,相比于整晚睡不着,工作受影响,还受到家人嫌弃、社交的尴尬,真的不要太划算!
建议趁优惠多买几瓶,给自己、伴侣、父母和孩子,一人健康,全家安心,一整年都不用再忍受脚臭、脚痒的痛苦了。为何不试一下呢?
扫描下方二维码,即可购买



